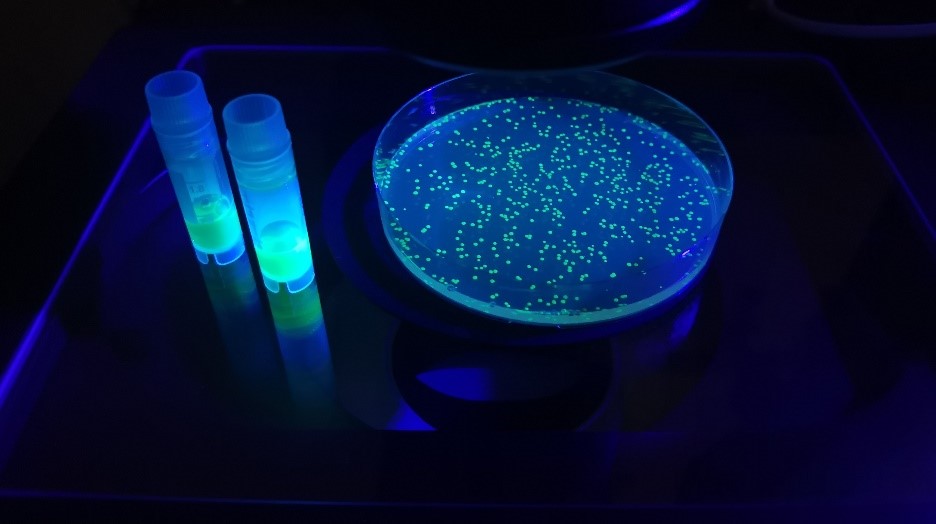

Воспаление — нормальный биологический процесс, который запускает наша иммунная система в ответ на попадание в организм патогенов или повреждение тканей. Некоторые специализированные клетки, прежде всего нейтрофилы и тканевые макрофаги, составляют первую линию обороны организма, и именно они способны поглощать и обезвреживать чужеродные агенты, а также продукты распада собственных поврежденных тканей — для этого они вырабатывают высоко реакционноспособные соединения.
«Поразительно, что клетки нашего организма могут производить даже такое агрессивное соединение, как гипохлорит анион, в быту это вещество мы называем хлоркой. Помимо активных форм хлора в организме вырабатываются и другие соединения со схожими химическими свойствами, которые можно объединить в общую группу гипогалогенных кислот и их производных», — рассказывает Дмитрий Билан, руководитель проекта по гранту РНФ, кандидат биологических наук, руководитель группы метаболических основ патологии ИБХ РАН.
Такие соединения производят клетки иммунной системы в борьбе с бактериальной инфекцией и различными паразитами. Кроме того, фермент, образующий гипогалогенные кислоты, содержится у нас в ротовой полости, дыхательных путях, слезе и даже грудном молоке. В норме эти соединения выполняют защитную функцию. Однако в результате нарушения регуляционных механизмов иммунные клетки могут стать причиной неконтролируемого развития гипогалогенного стресса, из-за которого происходит повреждение тканей и нарушение работы органов.
Сотрудники Института биоорганической химии имени академиков М. М. Шемякина и Ю. А. Овчинникова РАН (Москва) совместно с коллегами из других российских и зарубежных институтов разработали технологию, позволяющую отслеживать динамику гипогалогенных кислот и их производных в клетках и тканях. Для этого ученые создали белковую молекулу, состоящую из двух функциональных частей: сенсорной, специфично взаимодействующей с гипогалогенными кислотами, и флуоресцентной. Таким образом, свечение биосенсора, который исследователи назвали Hypocrates, изменяется в ответ на колебания концентрации гипогалогенных кислот в исследуемой системе.
Поскольку такой биосенсор кодируется геном, он может быть доставлен практически в любые типы клеток различных экспериментальных объектов. Авторы впервые показали динамику одновременно активных форм кислорода и хлора в воспаленных тканях рыб Danio rerio — популярного организма в современных исследованиях. С помощью нового инструмента Hypocrates ученым также удалось визуализировать в режиме реального времени динамику гипогалогенного стресса в бактериях, которые были захвачены нейтрофилами человека. В настоящий момент ученые заявляют, что новый инструмент полностью охарактеризован, протестирован в живых системах и готов для применения в медико-биологических исследованиях.
«Большинство патологических процессов сопровождается развитием воспалительных реакций. Поэтому создание новых инструментов для исследований в этой области имеет важное значение не только для понимания механизмов в основе того или иного заболевания, но и для разработок терапии лечения. Кроме того, наш инструмент интересен для поиска новых физиологических функций гипогалогенных кислот и их производных», — подводит итог Дмитрий Билан.